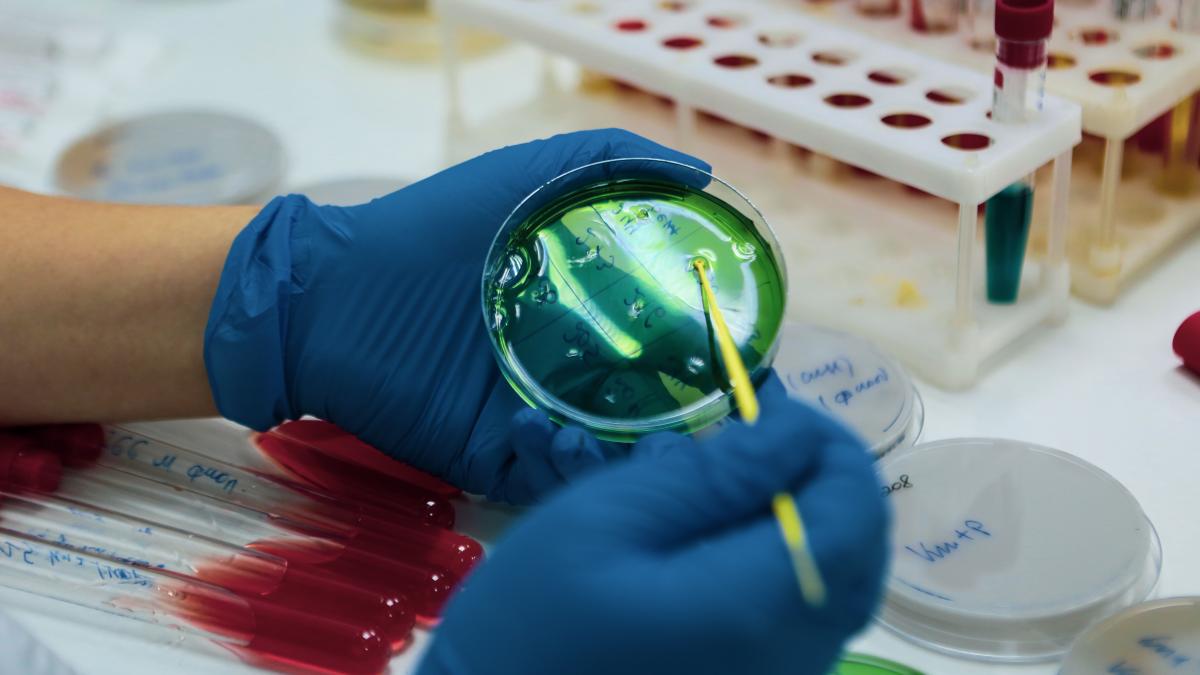

Амниотический мешок в чашке Петри живёт три месяца — что это значит для медицины будущего
Учёные создали уникальную модель амниотического мешка человека, выращенную из стволовых клеток. Эта структура точно воспроизводит состояние амниотического мешка в первые 2-4 недели после оплодотворения — самый ранний и критический этап эмбрионального развития. По словам исследователей, это самая совершенная и зрелая модель, когда-либо созданная в лаборатории.
Почему амниотический мешок так важен?
Амниотический мешок — это биологический "баллон", наполненный жидкостью, который окружает и защищает развивающийся эмбрион. Он амортизирует механические воздействия и обеспечивает необходимую среду для правильного роста. Наряду с плацентой амниотический мешок играет ключевую роль в поддержании жизни эмбриона.
Однако исследовать взаимодействия между эмбрионом и амниотической средой на ранних стадиях развития человека было сложно из-за этических и технических ограничений.
В чём уникальность новой модели?
Ранее лабораторные модели амниотического мешка не могли точно воспроизвести его трёхмерную структуру с двумя отдельными клеточными слоями. Кроме того, такие модели существовали лишь несколько дней, что не позволяло изучать длительный процесс формирования.
Новая модель, разработанная под руководством Сильвии Сантос из Института Фрэнсиса Крика (Лондон), получила название постгаструляционные амниоиды (ПГА). Они способны жить в чашках Петри до трёх месяцев и развиваются так же, как амниотический мешок у месячного эмбриона. По размеру они достигают примерно 2,5 сантиметров — "маленьких мячиков для гольфа", как описала сама учёная.
"Это доказывает, что эмбриональные стволовые клетки обладают невероятной способностью к самоорганизации, если им предоставить нужные условия", — отмечает Сантос.
Как создавали модель?
Исследователи начали с эмбриональных стволовых клеток, которые способны трансформироваться в любой тип клеток. С помощью специальных сигнальных молекул BMP4 и CHIR ученые запустили процесс формирования амниотического мешка. Они вводили BMP4 в течение первых 24 часов, затем добавляли CHIR на следующие 24 часа.
После этого клетки оставляли в покое в специальных круглодонных чашках, где они самостоятельно организовывались в характерную двухслойную структуру, наполненную жидкостью.
Что открыли учёные?
Особое внимание было уделено гену GATA3 — он способен превращать клетки в амниотические мешки без дополнительных сигналов. Этот ген регулирует другие важные гены, которые были задействованы в процессе культивирования (BMP4 и CHIR).
Чтобы понять, как амниотический мешок влияет на окружающие клетки, команда смешала ПГА с неспециализированными стволовыми клетками. Под воздействием ПГА они начали превращаться в разные типы клеток, демонстрируя способность мешка управлять развитием тканей вокруг себя.
Медицинский потенциал и перспективы
Амниотический мешок известен своими антимикробными и противовоспалительными свойствами. После планового кесарева сечения пациенты могут пожертвовать амниотические мешки для лечения ожогов или восстановления роговицы. Однако такие донорские материалы трудно стандартизировать.
"Теоретически ПГА могут стать надежным источником клеток для медицинских процедур", — подчеркнула Сантос.
Доцент Чжэн из Сиракузского университета, не участвовавший в исследовании, отметил, что нужны дополнительные испытания, чтобы подтвердить клиническую применимость моделей. Он добавил, что индуцированные плюрипотентные стволовые клетки (ИПСК), получаемые из собственных клеток пациента, могут стать особенно перспективным материалом для создания таких моделей.
Новые возможности в изучении врождённых заболеваний
Более точные модели амниотического мешка помогут понять, почему эта структура иногда развивается с нарушениями. Существуют врождённые заболевания, связанные с изменениями размера и состава амниотического мешка, и ПГА могут стать ключом к разгадке этих процессов.
"Я чрезвычайно воодушевлена потенциалом этих маленьких сооружений", — заключила Сантос, открывая новые горизонты в биологии и медицине.
Подписывайтесь на NewsInfo.Ru